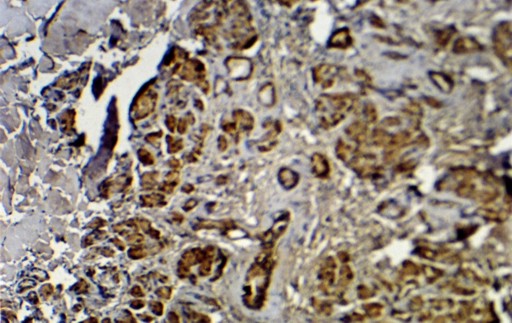

CASE REPORT
JOP. J Pancreas (Online) 2011 Sep 9; 12(5):458-460.
Heterotopic Pancreas of the Gallbladder Associated with Chronic Cholecystitis and High Levels of Amylasuria
Thanasis Klimis1, Nikolaos Roukounakis2, Ilias Kafetzis2, Vasileios Mouziouras2, Ilias Karantonis2, Nikolaos Andromanakos2
1Department of Pathology, Third Hospital of Social Insurance Institute; 2Department of Surgery, “Polykliniki” General Hospital. Athens, Greece
ABSTRACT
Context Heterotopic pancreas of the gallbladder is an extremely rare entity, especially when pancreatic tissue appears histologically with an exclusively exocrine structure. Case report We report the case of a 35-year-old man who presented with symptoms of acalculous gallbladder disease with high levels of amylasuria. Immunohistochemical analysis of the surgical specimen of the cholecystectomy revealed pancreatic tissue at the gallbladder wall. Conclusions Heterotopic pancreatic tissue is a rare pathological finding in the gallbladder. It requires consideration and sensitization in the differential diagnosis of acalculous gallbladder disease, which can explain hyperamylasuria in cases of unknown origin.
INTRODUCTION
Heterotopic pancreas is defined as the presence of pancreatic tissue which lacks anatomic and vascular continuity with the main pancreas [1]. In 90% of reported cases, heterotopic pancreas has been found in the upper gastrointestinal tract [2, 3, 4]. In addition, other locations of aberrant pancreatic tissue have occasionally been detected in the spleen, omentum, mediastinum, lungs, umbilicus, gallbladder and bile ducts [3, 5, 6, 7].
Heterotopic pancreas in the gallbladder is an extremely rare entity. Only thirty-three cases have been reported in the literature [2, 3, 4, 5, 6, 7, 8, 9, 10, 11, 12, 13, 14, 15, 16]. In the majority of cases, the heterotopic pancreas was an incidental finding following a cholecystectomy performed for symptomatic gallbladder disease.
We report the case of heterotopic pancreas which presented with clinical symptoms of cholecystitis and high levels of amylasuria.
CASE REPORT
A 35-year-old man was admitted to the hospital complaining of anorexia, nausea and abdominal pain. The onset of the pain was insidious, starting 48 hours previously and gradually worsening. On physical examination, the abdominal pain was located in the right upper quadrant. Palpation of the abdomen revealed tenderness and guarding in the right upper quadrant, and the Murphy sign was positive.
Furthermore, examination of the other systems did not disclose pathological findings. The patient’s temperature was 37.2°C. Laboratory data other than amylasuria (1,030 IU/L; reference range: 0-500 IU/L) were within the reference limits. The ultrasonographic study showed a small well-defined, non-mobile echogenic structure of 4 mm in diameter attached to the wall of the gallbladder. The features of the echogenic structure were suggestive of a gallbladder polyp (Figure 1) but not of a gallstone. Therefore, the most likely diagnosis was a gallbladder polyp and a laparoscopic cholecystectomy was carried out.
On macroscopic examination, the gallbladder was 70 mm long and 30 mm wide with a mural thickness of 60 µm. Gallstones were not present in the gallbladder lumen. An 8 mm intramural, yellow nodule was found in the body of the gallbladder. Its consistency was firm and it was protruding under the serosa.

|
Figure 1. An echogenic non-mobile structure attached to the gallbladder wall: features suggestive of a polyp. |
On microscopic examination of the gallbladder, a mixed chronic inflammation in the lamina propria, submucosa and muscular wall was found. The nodule showed ectopic pancreatic tissue, consisting of acini, ducts without any connection to the gallbladder lumen, and no islet cells (Figure 2).

|
Figure 2. Ectopic pancreas in the gallbladder. Pancreatic ducts, acinar component and gallbladder epithelium (H&E; original magnification x25). |
Immunohistochemical analysis was performed using a series of immunologic markers to identify this heterotopia. The ductal epithelium was surrounded by a smooth muscle component and exhibited a typical pancreatic duct-like immunophenotype, characterized by immunoreactivity to cytokeratins 7, 8, 18, 19 and to carbohydrate antigen (CA) 19-9. No reactivity against CEA, vimentin and CK20 was found. The pancreatic acini, composed of polygonal cells arranged in a single layer, with typical exocrine differentiation, were positive for alpha-1-antitrypsin and alpha-1-chymotrypsin (Figure 3). The other immunohistochemical markers, such as somatostatin, insulin and chromogranin A, were negative for endocrine activity.
|
Figure 3. Pancreatic tissue was reactive to alpha-1-chymotrypsin, demonstrating exocrine activity (alpha-1-chymotrypsin; original magnification x100). |
A subsequent diagnosis of chronic cholecystitis with heterotopic pancreas was reached. The patient’s postoperative course was uneventful and he was discharged on the 3rd postoperative day. After a follow-up of three months, the patient was asymptomatic without any discomfort.
DISCUSSION
Heterotopic pancreas is believed to result from early separation of the pancreas during rotation of the gastrointestinal tract in the embryonic stage. There is not a universally accepted theory as to the exact origin of this aberrant tissue [3, 4, 6].
Heterotopic pancreas can be found in all age groups. It is more frequent in men than in women [2, 7]. In one series of 212 cases of aberrant pancreas, only one case was found to be located in the gallbladder [4].
Heterotopic pancreas in the gallbladder presents as an exophytic growth and may be similar to polypoid lesions or as yellow-colored nodules, varying in dimension from a few millimeters to 4 cm. Fifty percent of heterotopic pancreatic tissue arises in the neck of the gallbladder [2, 3, 7, 8, 9, 14]. In our case, the heterotopic pancreas was subserosal. It is less common and is found in only 10% of cases. The submucosal presentation is most common and is found in 73% of cases [16].
Our histopathological examination revealed a heterotopic pancreas made up of exocrine acinar and ductal components without islet cells, corresponding to incomplete heterotopia. Islets of Langerhans are identified in only one-third of cases [16].
An immunohistochemical study was carried out to identify and characterize the endocrine and exocrine activity in the ectopic pancreas situated in the gallbladder. The literature contains only a few reports concerning the immunohistochemical profile [7, 9]. We used an ample variety of immunologic markers. Vimentin is a marker of pancreatic precursor cells and has been used by Ko et al. [17] as expression in proliferative duct cells. However, Beltran and Barria [7], and Pilloni et al. [9], reported the negative immunoreactivity in pancreatic duct cells to vimentin as happened in our case. Tubular and epithelial structures were immunoreactive to cytokeratins 7, 8, 18, and 19, and to CA 19-9. Exocrine activity was identified by immunoreactivity to alpha-1-antitrypsin and alpha-1-chymotrypsin but endocrine activity was not.
Most patients with heterotopic pancreas are asymptomatic, and the heterotopic tissue is found incidentally at histological exam following a cholecystectomy. Heterotopic pancreas in the gallbladder is rarely symptomatic. The manifestation of symptoms is largely associated with acute or chronic cholecystopathy, with or without gallstones [5, 6, 7, 13, 14, 16]. Qizilbash [12], reported a case in which the cause of acute symptoms was the inflammation of the heterotopic pancreatic tissue, resembling acute pancreatitis.
Inceoglu et al. [11] reported a case of heterotopic pancreas in the cystic duct with hydrops of the gallbladder and chronic pancreatitis due to ectopic tissue. In three cases similar to our case, heterotopic pancreas has been found to stimulate cholecystopathy with all symptoms disappearing after a cholecystectomy. Malignant transformation of an ectopic pancreas may occasionally occur [10].
The mechanism whereby this aberrant tissue may produce various symptoms is unclear. Previous studies [18] have suggested that active pancreatic enzymes, such as amylase and trypsin, refluxing into the biliary tract and gallbladder lumen might produce inflammation, spasm and biliary symptoms in patients without gallstones, and acute cholecystitis in patients with gallstones [6, 7, 13, 16, 18].
In our case, we could hypothesize that the cause of gallbladder symptomatology may have been due to the continuous secretion of active pancreatic enzymes, mainly amylase, directly into the gallbladder lumen, causing damage to the epithelium and producing symptoms associated with chronic inflammation.
The preoperative diagnosis of an aberrant pancreas in the gallbladder is impossible using the imaging exams currently available. Ultrasonography and computed tomography cannot distinguish an aberrant pancreas in the gallbladder from other lesions, such as cholesterol polyps, adenoma and carcinoma [14].
However, an ectopic pancreas in the gallbladder, despite its rarity, should be considered in the differential diagnosis of acalculous lesions, such as polypoid formations, isolated parietal thickenings or nodulations, especially when these coexist with hyperamylasuria of unknown origin.
Received February 13th - Accepted April 20th, 2011
Key words Choristoma; Gallbladder, Immunohistochemistry; Pancreas
Conflict of interest The authors have no potential conflicts of interest
Correspondence
Nicolaos
Roukounakis
Department of Surgery
General Hospital “Polykliniki”
Athens
Greece
Phone: +30-21.0204.4123
Fax: +30-21.0524.0130
E-mail: nicrouk@hotmail.com
References
1. Hsia CY, Wu CW, Lui WY. Heterotopic pancreas: A difficult diagnosis. J Clin Gastroenterol 1999; 28:144-7. (More details: [1]).
2. Neupert G, Appel P, Braun S, Tonus C. Heterotopic pancreas in the gallbladder. Diagnosis, therapy and course of a rare developmental anomaly of the pancreas. Chirurg 2007; 78:261-4. (More details: [2]).
3. Lai EC, Tompkins RK. Heterotopic pancreas. Review of a 26 year experience. Am J Surg 1986; 151:697-700. (More details: [3]).
4. Dolan RV, Remine WH, Dockery MB. The fate of heterotopic pancreatic tissue. Arch Surg 1974; 109:762-5. (More details: [4]).
5. Al-Shraim M, Rabie ME, Elhakeem H, Kandeel A, Shah MT, Jamil S. Pancreatic heterotopia in the gallbladder associated with chronic cholecystitis: A rare combination. JOP. J Pancreas (Online) 2010; 11:464-6. (More details: [5]).
6. Bromberg SH, Franco MI, Franca LCM, Neto CC. Pancreatic heterotopia in the gallbladder: a case report and literature review. Einstein 2009; 7:215-8. (More details: [6]).
7. Beltran MA, Barria C. Heterotopic pancreas in the gallbladder: the importance of an uncommon condition. Pancreas 2007; 34:488-91. (More details: [7]).
8. Ben-Baruch D, Sandbank Y, Wolloch Y. Heterotopic pancreas in the gallbladder. Acta Chir Scand 1986; 152:557-8. (More details: [8]).
9. Pilloni L, Cois A, Uccheddu A, Ambu R, Coni P, Faa G. Complete pancreatic heterotopia of gallbladder with hypertrophic duct simulating an adenomyoma. World J Gastroenterol 2006; 12:1786-7. (More details: [9]).
10. Jeng KS, Yang KC, Kuo SH. Malignant degeneration of heterotopic pancreas. Gastrointest Endosc 1991; 37:196-8. (More details: [10]).
11. Inceoglu R, Dosluoglu HH, Kullu S, Ahiskali R, Doslu FA. An unusual cause of hydropic gallbladder and biliary colic. Heterotopic pancreatic tissue in the cystic duct: report of a case and review of the literature. Surg Today 1993; 23:532-4. (More details: [11]).
12. Qizilbash AH. Acute pancreatitis occurring in heterotopic pancreatic tissue in the gallbladder. Can J Surg 1976; 19:413-4. (More details: [12]).
13. Shiwani MH, Gosling J. Heterotopic pancreas of the gallbladder associated with chronic cholecystitis. JOP. J Pancreas (Online) 2008; 9:30-2. (More details: [13]).
14. Kondi-Paphiti A, Antoniou AG, Kotsis T, Polimeneas G. Aberrant pancreas in the gallbladder wall. Eur Radiol 1997; 7:1064-7. (More details: [14]).
15. Jarde O, Barrat JP, Degardin P, Maingueux P, Tardif B. Aberrant pancreas in the gallbladder. J Chir 1989; 126:476-77. (More details: [15]).
16. Weppner JL, Wilson MR, Ricca R, Lucha PA Jr. Heterotopic pancreatic tissue obstructing the gallbladder neck: a case report. JOP. J Pancreas (Online) 2009; 10:532-4. (More details: [16]).
17. Sai JK, Ariyama J, Suyama M, Kubokawa Y, Sato N. Occult regurgitation of pancreatic juice into the biliary tract: diagnosis with secretin injection, magnetic resonance cholangiopancreatography. Gastrointest Endosc 2002; 56:929-32. (More details: [17]).
18. Ko SH, Suh SH, Kim BJ, Ahn YB, Song KH, Yoo SJ, et al. Expression of the intermediate filament Vimentin in proliferating duct cells as a marker of pancreatic precursor cells. Pancreas 2004; 28:121-8. (More details: [18]).